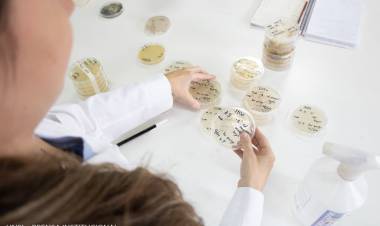
Científicos de San Luis analizan levaduras autóctonas

BATAVIA: se vienen obras clave para la localidad sureña

“Comparto la felicidad del intendente de Batavia Diego Segel, por las obras que este martes se pusieron en marcha en su localidad”, dijo Gato Fernández quien estuvo de visita porel departamento Dupuy
Por un lado destacó la construcción de desagües pluviales que solucionará un viejo reclamo de los vecinos que en épocas de intensas lluvias no podían transitar por las calles como consecuencia de las inundaciones y anegamientos.
Para evitar estos trastornos, el Ministerio de Obras Públicas e integrantes, anunció que se hará un canal a cielo abierto de hormigón armado y la inversión será de casi 200 millones de pesos.
El otro motivo de festejo se dio con el anuncio de 10 viviendas sociales con todos los servicios de Infraestructura, por un monto de 163 millones de pesos.
“A las familias que participaron del acto, les expresé que mi gobierno se caracterizará por el trabajo mancomunado que haré con todos los intendentes desgranando todas las políticas del Estado con un sentido bien federal, llegando a todos los pobladores de la provincia. Además, con la construcción masiva de viviendas, 10 mil en cuatro años, se generarán miles de puestos de trabajo”.

Comentarios (0)